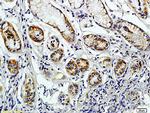
CD38 Antibody in Immunohistochemistry (Paraffin) (IHC (P))

Search
Bioss
CD38 Polyclonal Antibody
{{$productOrderCtrl.translations['antibody.pdp.commerceCard.promotion.promotions']}}
{{$productOrderCtrl.translations['antibody.pdp.commerceCard.promotion.viewpromo']}}
{{$productOrderCtrl.translations['antibody.pdp.commerceCard.promotion.promocode']}}: {{promo.promoCode}} {{promo.promoTitle}} {{promo.promoDescription}}. {{$productOrderCtrl.translations['antibody.pdp.commerceCard.promotion.learnmore']}}
产品信息
BS-0980R
种属反应
宿主/亚型
分类
类型
抗原
偶联物
形式
浓度
规格
纯化类型
保存液
内含物
保存条件
运输条件
靶标信息
CD38 is a multifunctional ectoenzyme and type II transmembrane glycoprotein involved in various cellular processes. It catalyzes the conversion of NAD into secondary messengers such as nicotinic acid adenine dinucleotide phosphate (NAADP) and cyclic ADP-ribose (cADPR). CD38 plays a crucial role in B cell development, with expression levels fluctuating from high in immature cells to low in intermediate ones, and back to high in mature B cells. It is also present in a variety of tissues and hematopoietic cells, including T cells, NK cells, and monocytes, and is used to phenotype leukemias and monitor HIV-1 progression. The CD34+CD38- population is considered to define the most pluripotent hematopoietic stem cells. In addition to its surface expression, CD38 has been identified in the nucleus, where it may regulate calcium levels. It functions as a multi-catalytic ectoenzyme, serving roles as an ADP-ribosyl cyclase, cyclic ADP-ribose hydrolase, and possibly NAD+ glycohydrolase, or as a cell surface receptor. CD38 is involved in the activation, proliferation, and differentiation of mature lymphocytes and mediates apoptosis of myeloid and lymphoid progenitor cells. It also participates in cell adhesion, signal transduction, and calcium signaling. Antibodies to CD38 are valuable for subtyping lymphomas and leukemias, detecting plasma cells (such as in myelomas), and marking activated B and T cells. CD38 is expressed at high levels in the pancreas, liver, kidney, malignant lymphoma, and neuroblastoma. Dysfunctions in CD38 are associated with diseases like chronic lymphocytic leukemia and Richter's Syndrome.
仅用于科研。不用于诊断过程。未经明确授权不得转售。
篇参考文献 (0)
生物信息学
蛋白别名: 2'-phospho-ADP-ribosyl cyclase; 2'-phospho-ADP-ribosyl cyclase/2'-phospho-cyclic-ADP-ribose transferase; 2'-phospho-cyclic-ADP-ribose transferase; ADP-ribosyl cyclase 1; ADP-ribosyl cyclase/cyclic ADP-ribose hydrolase 1; ADPRC 1; cADPR hydrolase 1; CD38; CD38 antigen (p45); CD38 antigen p45; cluster of differentiation 38; Cyclic ADP-ribose hydrolase 1; ecto-nicotinamide adenine dinucleotide glycohydrolase; lymphocyte differentiation antigen CD38; NAD(+) nucleosidase; NAD+ nucleosidase; T10; unnamed protein product
基因别名: ADPRC 1; ADPRC1; cADPR1; CD38
UniProt ID: (Human) P28907
Entrez Gene ID: (Human) 952